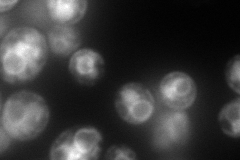
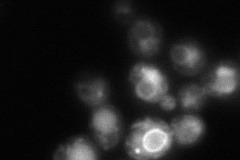

View description
Endoplasmic reticulum protein that functions, together with other assembly factors, in assembly of the V0 sector of the vacuolar ATPase (V-ATPase); null mutation enhances the V-ATPase deficiency of a vma21 mutant impaired in ER retrieval
Localization:
Intensity:
Fold change:
Significance:
-
C’ GFP library in SD

vacuole membrane119.12 -
N' NOP1pr-GFP in SD
vacuole membrane176.9 -
N' TEF2pr-mCherry in SD

ER,vacuole89.6471 -
N' NATIVEpr-GFP in SD
ER,vacuole82.96 -
N' TEF2pr-VC and Cyto-VN in SD

#N/A0 -
C’ GFP library in SD+DTT

vacuole membrane95.380.8No -
C’ GFP library in SD+H2O2

vacuole membrane114.470.96No -
C’ GFP library in Starvation Media

vacuole membrane283.882.38Yes -
C’ GFP library on the background of Pup2-DaMP

vacuole membrane -
C’ GFP library on the background of CCT mutant

vacuole membrane106.7650.896188No
